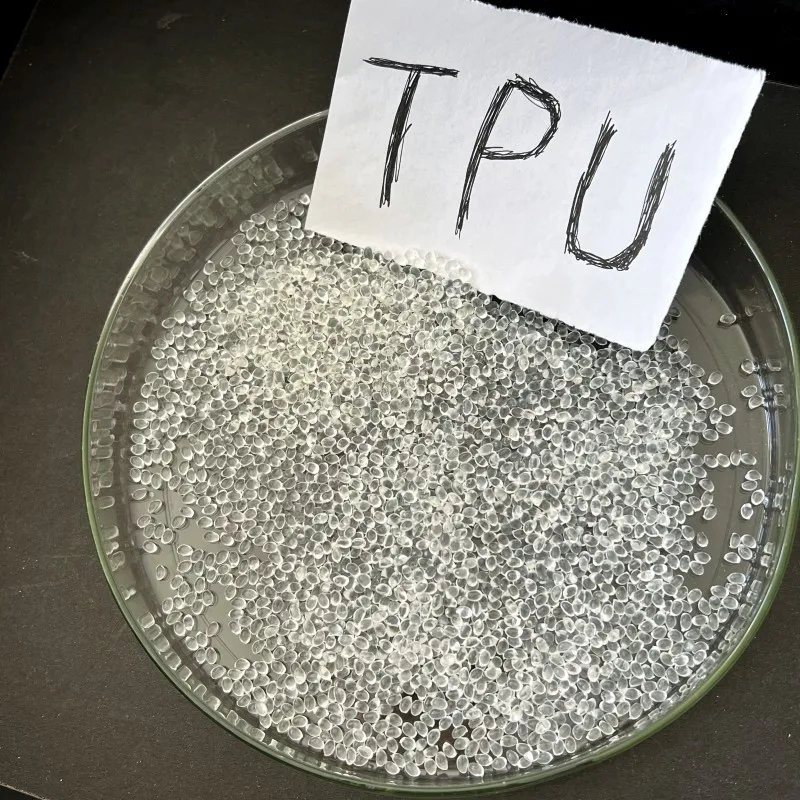

Высококачественный инженерный пластик термопластичный полиуретан полимерная смола Inov Базовая Серия гранул ТПУ 50D 60A 70A 80A
- Категория: Thermoplastic Elastomers >>>
- Поставщик: Hebei,Lideng,Import,&,Export,Co.,Ltd.
Поделиться:
Описание и отзывы
Трекер стоимости
| Месяц | Минимальная цена | Макс. стоимость |
|---|---|---|
| Aug-17-2025 | 1.23 $* | 1.8 $* |
| Jul-17-2025 | 1.93 $* | 1.33 $* |
| Jun-17-2025 | 1.87 $* | 1.89 $* |
| May-17-2025 | 1.39 $* | 1.6 $* |
| Apr-17-2025 | 1.79 $* | 1.21 $* |
| Mar-17-2025 | 1.89 $* | 1.77 $* |
| Feb-17-2025 | 1.32 $* | 1.84 $* |
| Jan-17-2025 | 1.3 $* | 1.20 $* |
Характеристики
Products Description

TPU
TPU (Thermoplastic polyurethanes) is a highly versatile elastomer with unique properties that offers both superior performance and processing flexibility. TPU is the ideal polymer for applications in a wide variety of markets, including footwear, wire and cable, film and sheet, compounding, adhesives and specialty molded parts.
TPU is a unique type of plastic bridging the gap between rubbers and plastics. The key to TPU's versatility is that its hardness can be highly customized. TPU can be as soft as rubber or as hard as rigid plastics. The look and feel of TPU is just as versatile. It can be transparent or colored as well as smooth to the touch or provide grip.
TPU is a unique type of plastic bridging the gap between rubbers and plastics. The key to TPU's versatility is that its hardness can be highly customized. TPU can be as soft as rubber or as hard as rigid plastics. The look and feel of TPU is just as versatile. It can be transparent or colored as well as smooth to the touch or provide grip.
Details Images





Product Specification
Item | Value |
Product Name | TPU Granules |
Place of Origin | Hebei, China |
Brand Name | Hebei Lideng |
Color | Natural |
Feature | Eco-Friendly |
Grade | Injection Grade; Extrusion Grade |
Material | 100% Thermoplastic Polyurethane |
Sample | Available |
Usage | Injection Molding Products |
Application
Automobile parts: ball coupling, dust cover, pedal brake, door lock pin, bushing, plate spring bushing, bearing, shockproof parts, internal and external decorative parts, anti-slip chain, etc.
Mechanical and industrial parts: all kinds of gears, seals, shockproof parts, mold needles, bushings, bearings, covers, connectors, rubber screens, printing cots, etc.
Others: footwear, pipe, hose, film, plate, wire, cable, all kinds of annular pipelines, all kinds of containers, ink connection materials, etc.




Company Profile
Hebei Lideng Import and Export Co.,LTD
Lideng company is a comprehensive utilization enterprise of renewable resources that specializes in the research and development of waste plastics production and processing of plastic particles. The company is located in Xingtai, Hebei Province, an important industrial town in China, covering an area of 25000 square meters and a construction area of 12000 square meters. It now has more than 50 employees, mainly producing processing Polypropylene and polyethylene plastic particles. ABS plastic particles, PP plastic particles, PS plastic particles, PA plastic particles, tpe/asa/pom plastic particles. With an annual output of 5000 tons, it now has a professional production base and advanced manufacturing technology. It supplies recycled abs, pp, ps, pa recycled particles all year round. The quality is stable and reliable, and the enterprise has a good reputation. You are welcome to visit our factory at any time for inspection and guidance. We hope you can contact us. The company is close to Beijing Guangzhou and Beijing Kowloon transportation arteries, with convenient transportation, adjacent to Qingdao port and Tianjin port, and developed maritime transportation.

With a total investment of 50million yuan, the company has built four polypropylene (PP) waste plastic particle production lines and two polyethylene (PE) waste plastic particle production lines, forming a scale with an annual output of 30000 tons (including 20000 tons of polypropylene and 10000 tons of polyethylene) of recycled plastic particles, achieving an annual operating income of 100million yuan and profits and taxes of 20million yuan. The polypropylene (PP) and polyethylene (PE) recycled plastic particles produced by the company are of good quality and meet industry standards. The products are sold all over Shandong Province and are highly praised by users.
Product packaging


Why Choose Us

FAQ
Q1. Are you factory or only company?
A1. We are an industry and trade integration of enterprises in Shijiazhuang, Hebei province.
Q2. What can you buy from us?
A2. ABS, EVA, HDPE, LDPE, LLDPE, GPPS, HIPS, PP, PVC in various grades and color.
Q3. How about your delivery time?
A3. Generally it is 5-10 days, if we have stock. If not, maybe need 15-20 days to arrange the shipping.
Q4. Do you provide samples?
Q5. How can we guarantee quality?
A5. Always a pre-production sample before mass production;
We carefully sorted before production and inspect them before delivery.
Q6. What is your payment term?
A6. We accept all payment TT, LC, Western Union, Paypal.
A1. We are an industry and trade integration of enterprises in Shijiazhuang, Hebei province.
Q2. What can you buy from us?
A2. ABS, EVA, HDPE, LDPE, LLDPE, GPPS, HIPS, PP, PVC in various grades and color.
Q3. How about your delivery time?
A3. Generally it is 5-10 days, if we have stock. If not, maybe need 15-20 days to arrange the shipping.
Q4. Do you provide samples?
A4. We are honored to offer you free samples, just need to pay freight cost.
Q5. How can we guarantee quality?
A5. Always a pre-production sample before mass production;
We carefully sorted before production and inspect them before delivery.
Q6. What is your payment term?
A6. We accept all payment TT, LC, Western Union, Paypal.